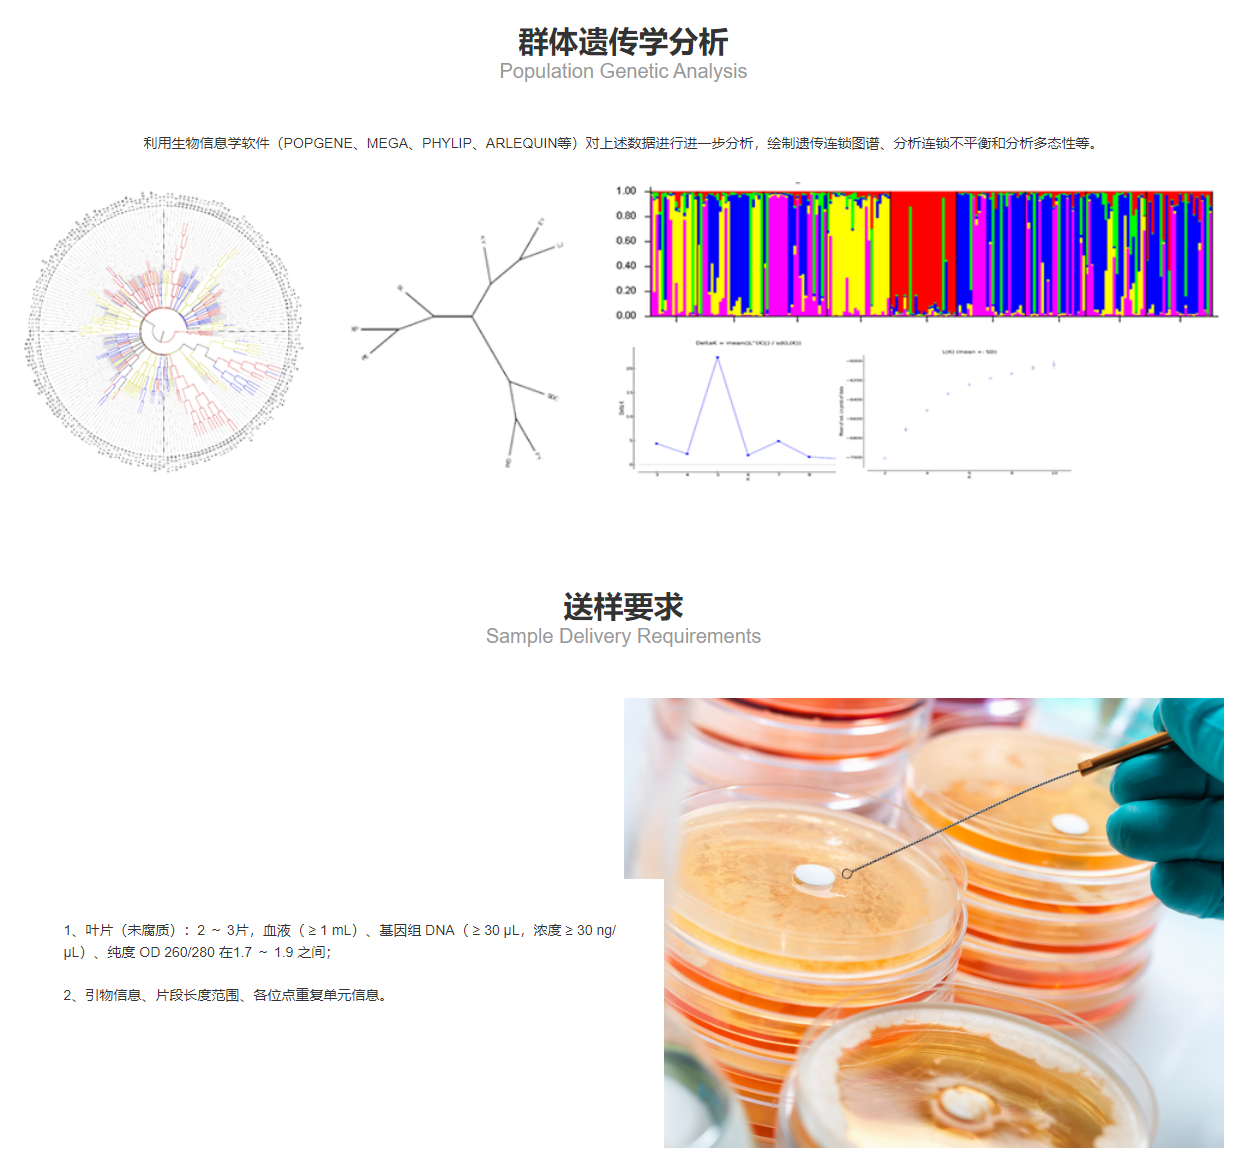

SSR/STR检测
- QK-10
- 擎科
- 北京市
- 一个月内
- 按需定制
- 议价
- 2022-12-01 20:07:23
北京擎科生物科技有限公司
一键申请试用
咨询
加入意向单
联系方式
微卫星标记(Microsatellite)也称为短串联重复序列(STR)或简单重复序列(SSR),是广泛分布在真核生物基因组中的简单重复序列。微卫星位点通常通过PCR扩增和电泳检测,并根据片段大小分离等位基因进行分析;扩增后的等位微卫星利用ABI3730遗传分析仪对荧光标记的DNA片段进行检测,结合分子量内标进行DNA片段长度计算,使SSR/STR分型变得高效快捷、精确。
实验原理Experimental Principle